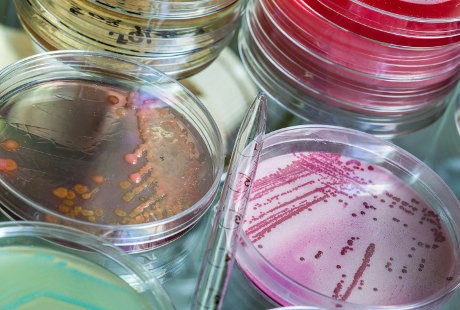

Ya, seperti dirangkum detikHealth dari berbagai sumber pada Jumat (15/5/2015), berikut 5 kisah tak biasa mereka yang 'ingin' sakit dan mendapatkan perawatan khusus dari tim medis:
1. Pura-pura nyeri dada
|
|
Pemulihan pasca tindakan pun menunjukkan bahwa ia dalam kondisi baik-baik saja, namun bukannya pulang, ia justru terus membuat keluhan. Setelah pihak rumah sakit memeriksa riwayatnya, semua keluhan tersebut ternyata palsu.
Pria tersebut sebelumnya telah dirawat di banyak rumah sakit yang berbeda, bahkan di negara yang berbeda, dengan keluhan yang sama. Akhirnya ia pun dirujuk ke psikiater.
Tak disangka, pada tahun 2009, ia muncul di sebuah rumah sakit wilayah Ohio dengan metode yang sama. Ia mengeluh terkena tumor otak. Namun kali ini ia mengaku tidak bisa menjalani MRI dan minum berbagai obat karena alergi. Dokter di rumah sakit Ohio kemudian menyadari bahwa pasien ini kerap melakukan hal yang sama, namun dengan nama dan tanggal lahir berbeda-beda, selama enam tahun terakhir.
2. Mengaku diabetes tiap akhir pekan
|
|
Hasil pemeriksaan tak menunjukkan adanya keanehan tersebut. Namun setelah diperiksa lebih lanjut, terungkap bahwa ia memiliki jadwal tersendiri untuk datang ke rumah sakit. Biasanya wanita ini datang ke rumah sakit seiap akhir pekan, di mana saat itu suaminya sedang pergi dinas dalam perjalanan. Setelah dibawa ke psikiater, diduga ia sengaja melakukan ini untuk mendapatkan perhatian saat suaminya pergi.
3. Suntikkan bakteri ke tubuh sendiri
|
|
Oleh sebab itu, dokter kemudian melakukan pengujian ekstensif. Tes menunjukkan tidak ada masalah dengan sistem kekebalan tubuh wanita tersebut, serta tidak ada sepsis. Namun fakta bahwa wanita itu adalah seorang teknolog medis menimbulkan kecurigaan di kalangan dokter. Kamarnya pun digeledah selama ia berada di ruangan lain untuk dilakukan rontgen.
Dokter menemukan sebuah tas yang berisi cawan petri dengan koloni bakteri E.coli dan S.aureus tumbuh di dalamnya. Selain itu terdapat pula jarum suntik dan tourniquet. Ia pun dibawa ke psikiater mendapatkan bantuan lebih lanjut.
4. Memalsukan kanker
|
|
Namun yang diterima oleh dokter tersebut adalah catatan yang tampaknya dibuat sendiri. Kertas tersebut adalah kertas fotokopian dan tidak tampak seperti catatan medis. Setelah dikonfirmasi, ia rupanya sudah beberapa kali pergi ke rumah sakit lain dengan keluhan dan catatan yang sama.
5. Pura-pura memar dengan spidol
|
|
Dokter kulit menduga memar tersebut adalah ekimosis. Namun karena penglihatannya tetap normal dan ruam tersebut tampaknya memiliki bentuk yang aneh serta warna yang agak aneh, tim medis pun mencoba mengusapnya dengan tisu alkohol. Rupanya warna tersebut menghilang dan luntur di tisu.
Akhirnya gadis tersebut pun mengakui telah mewarnainya sendiri dengan menggunakan spidol berwarna ungu.
Halaman 2 dari 6